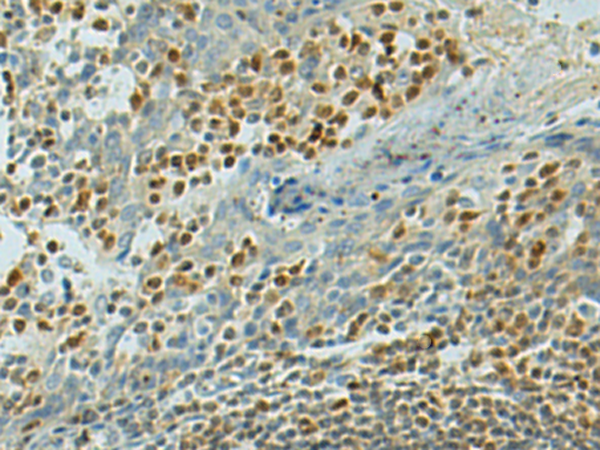

|
Background: |
Transcription factor that specifically recognizes and binds E-box sequences (5'-CANNTG-3'). Efficient DNA-binding requires dimerization with itself or with another MiT/TFE family member such as TFE3 or MITF. In association with TFE3, activates the expression of CD40L in T-cells, thereby playing a role in T-cell-dependent antibody responses in activated CD4+ T-cells and thymus-dependent humoral immunity. Specifically recognizes and binds the CLEAR-box sequence (5'-GTCACGTGAC-3') present in the regulatory region of many lysosomal genes, leading to activate their expression. It thereby plays a central role in expression of lysosomal genes. Acts as a positive regulator of autophagy by promoting expression of genes involved in autophagy. Specifically recognizes the gamma-E3 box, a subset of E-boxes, present in the heavy-chain immunoglobulin enhancer. Plays a role in the signal transduction processes required for normal vascularization of the placenta. Regulates lysosomal positioning in response to nutrient deprivation by promoting the expression of PIP4P1 (PubMed:29146937). |
|
Applications: |
ELISA, IHC |
|
Name of antibody: |
TFEB |
|
Immunogen: |
Fusion protein of human TFEB |
|
Full name: |
transcription factor EB |
|
Synonyms: |
TCFEB; BHLHE35; ALPHATFEB |
|
SwissProt: |
P19484 |
|
ELISA Recommended dilution: |
5000-10000 |
|
IHC positive control: |
Human tonsil and Human gastric cancer |
|
IHC Recommend dilution: |
50-200 |

購物車
購物車 幫助
幫助
 021-54845833/15800441009
021-54845833/15800441009
